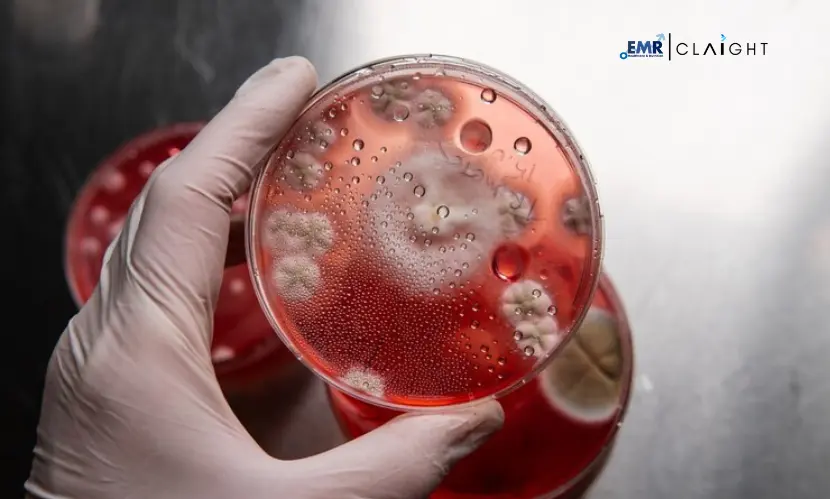

The haemoglobinopathies market was valued at USD 7.57 Billion in 2025, driven by the increasing incidence of thalassemia and sickle cell anemia across the 8 major markets. The market is expected to grow at a CAGR of 9.70% during 2026-2035, reaching USD 19.11 Billion by 2035.
Haemoglobinopathies refer to a group of inherited blood disorders in which the structure or production of the protein component of red blood cells, haemoglobin, is affected. These disorders are not gender-linked and some regions of the world show more prevalence of haemoglobinopathies than the other. For instance, sickle cell disease is reported to be the most common in India and West Africa whereas thalassaemia major is more prevalent in Asia and Mediterranean countries.
Recent data indicates that sickle cell disease affects 20 million people worldwide, with over 100,000 people in the United States living with the condition. Further, it is estimated that around 1 in 13 Black or African American babies are born with sickle cell disease. The rising burden of genetic blood disorders is one of the primary drivers of the market, propelling the demand for advanced diagnostic methods and effective treatments. In addition, increased research and development efforts focused on curative treatments, gene therapy, and novel drugs are expected to fuel the market growth.
In December 2023 , a major milestone was achieved in the haemoglobinopathies market, with the U.S. Food and Drug Administration (FDA) approving two gene therapies for the treatment of sickle cell disease. Casgevy, developed by partners Vertex Pharmaceuticals and CRISPR Therapeutics, became the FDA-approved treatment to utilize CRISPR gene editing technology. Lyfgenia, developed by Bluebird Bio, is a cell-based gene therapy approved for sickle cell disease patients aged 12 years and older. The surge in regulatory approvals of such innovative treatments is projected to elevate the market value.
The market also benefits from the growing awareness about genetic disorders along with increased government-supported initiatives for early screening and treatment, which has boosted the demand for haemoglobinopathy management solutions. Moreover, the growth in programs aimed at screening newborns and high-risk populations is anticipated to support market expansion in the coming years.
Top Companies Leading the Haemoglobinopathies Market in 2026
1. Bluebird Bio, Inc.
| Headquarters: |
Massachusetts, United States |
| Establishment: |
1992 |
| Website: |
https://www.bluebirdbio.com |
Bluebird Bio is a biotechnology company that is known for developing gene therapies for the treatment of severe genetic disorders including haemoglobinopathies. In December 2023 , the company announced the FDA approval of its gene therapy LYFGENIA™ (lovotibeglogene autotemcel) for people with sickle cell disease aged 12 years and older and carrying a history of vaso-occlusive events. Bluebird Bio is also known to invest heavily in clinical trials to expand the indications for its existing therapies and explore new gene-editing technologies.
2. Emmaus Medical, Inc.
| Headquarters: |
California, United States |
| Establishment: |
1987 |
| Website: |
https://www.emmausmedical.com |
Emmaus Medical, Inc. is a commercial-stage biopharmaceutical company that develops and commercializes innovative treatments with a focus on rare and orphan diseases such as sickle cell disease. The company’s Endari is the first FDA-approved oral glutamine therapy that can help in the reduction of acute complications linked with sickle cell disease in adults and pediatric patients (5 years and above). In February 2024 , the Puerto Rico Department of Health granted marketing authorization to Endari® (L-glutamine oral powder), giving access to an important sickle cell disease therapy to patients living in Puerto Rico.
3. Prolong Pharmaceuticals, LLC.
| Headquarters: |
South Plainfield, New Jersey, United States |
| Establishment: |
2005 |
| Website: |
https://prolongpharma.com/ |
Prolong Pharmaceuticals is a privately held biotech company that has a prominent presence in the haemoglobinopathies market. The company specializes in developing treatments for sickle cell anemia, diabetic ischemia, and several trauma indications. Prolong Pharmaceuticals' lead candidate is PP-007 (SANGUINATE®, PEGylated carboxyhemoglobin bovine) which is currently undergoing clinical development for sickle cell disease and ischemic conditions, among others.
4. Novartis AG
| Headquarters: |
Basel, Switzerland |
| Establishment: |
1996 |
| Website: |
https://www.novartis.com |
Based in Basel, Switzerland, Novartis AG is a major pharmaceutical corporation with a focus on expanding access to its sickle cell treatments globally. The company is investing in new research areas, including gene therapy and combination therapies, to find innovative solutions for haemoglobinopathies. The company's sickle cell medicine Adakveo® is approved in the United States and Europe and is the first targeted sickle cell disease therapy designed to prevent recurrent vaso-occlusive crises (VOCs) in sickle cell disease patients aged 16 years and above.
5. Pfizer, Inc.
| Headquarters: |
New York, United States |
| Establishment: |
1849 |
| Website: |
https://www.pfizer.com |
This American multinational pharmaceutical and biotechnology corporation is one of the key players in the market. Pfizer is actively involved in the research and development of new therapies for haemoglobinopathies, with special emphasis on gene therapy and other innovative treatment approaches. The company leverages strategic research collaborations and partnerships to strengthen its position in the market. For instance, in October 2022 , Pfizer completed the acquisition of sickle cell disease drugmaker Global Blood Therapeutics, Inc. to expand its sickle cell disease portfolio.
6. Sangamo Therapeutics, Inc.
| Headquarters: |
California, United States |
| Establishment: |
1995 |
| Website: |
https://www.sangamo.com |
Based in Brisbane, California, Sangamo Therapeutics, Inc. is a clinical-stage genomic medicine company specializing in the creation of technologies that enable gene-based therapeutic development. The company utilizes its zinc finger nuclease (ZFN) technology to develop potential treatments for haemoglobinopathies. Sangamo’s pipeline includes gene-editing therapies for sickle cell disease and beta-thalassemia, which are designed to target the underlying genetic mutations of the genetic disorders. The company intends to advance its clinical trials and form strategic partnerships for the efficient commercialization of its products.

Share